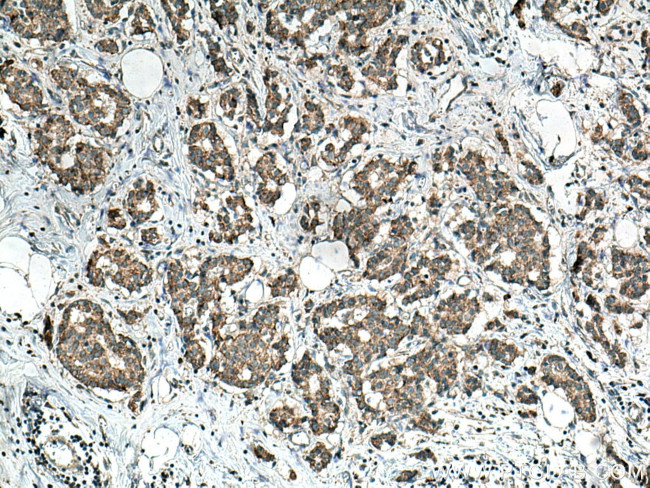
HSDL1 Antibody in Immunohistochemistry (Paraffin) (IHC (P))

Search
Proteintech
HSDL1 Polyclonal Antibody
{{$productOrderCtrl.translations['antibody.pdp.commerceCard.promotion.promotions']}}
{{$productOrderCtrl.translations['antibody.pdp.commerceCard.promotion.viewpromo']}}
{{$productOrderCtrl.translations['antibody.pdp.commerceCard.promotion.promocode']}}: {{promo.promoCode}} {{promo.promoTitle}} {{promo.promoDescription}}. {{$productOrderCtrl.translations['antibody.pdp.commerceCard.promotion.learnmore']}}
产品信息
16988-1-AP
种属反应
宿主/亚型
分类
类型
抗原
偶联物
形式
浓度
规格
纯化类型
保存液
内含物
保存条件
运输条件
产品详细信息
Immunogen sequence: MAAVDSFYL LYREIARSCN CYMEALALVG AWYTARKSIT VICDFYSLIR LHFIPRLGSR ADLIKQYGRW AVVSGATDGI GKAYAEELAS RGLNIILISR NEEKLQVVAK DIADTYKVET DIIVADFSSG REIYLPIREA LKDKDVGILV NNVGVFYPYP QYFTQLSEDK LWDIINVNIA AASLMVHVVL PGMVERKKGA IVTISSGSCC KPTPQLAAFS ASKAYLDHFS RALQYEYASK GIFVQSLIPF YVAASMTAPS NFLHRCSWLV PSPKVYAHHA VSTLGISKRT TGYWSHSIQF LFAQYMPEWL WVWGANILNR SLRKEALSCT A (1-330 aa encoded by BC018084)
靶标信息
HSDL1 gene ontology annotations related to this gene include oxidoreductase activity.
仅用于科研。不用于诊断过程。未经明确授权不得转售。
生物信息学
蛋白别名: Inactive hydroxysteroid dehydrogenase-like protein 1; Short chain dehydrogenase/reductase family 12C member 3; steroid dehydrogenase-like protein; unnamed protein product
基因别名: 2700067E09Rik; HSDL1; RGD1308433; SDR12C3
UniProt ID: (Human) Q8NC98, (Mouse) Q8BTX9, (Rat) Q4V8B7
Entrez Gene ID: (Human) 83693, (Mouse) 72552, (Rat) 361418